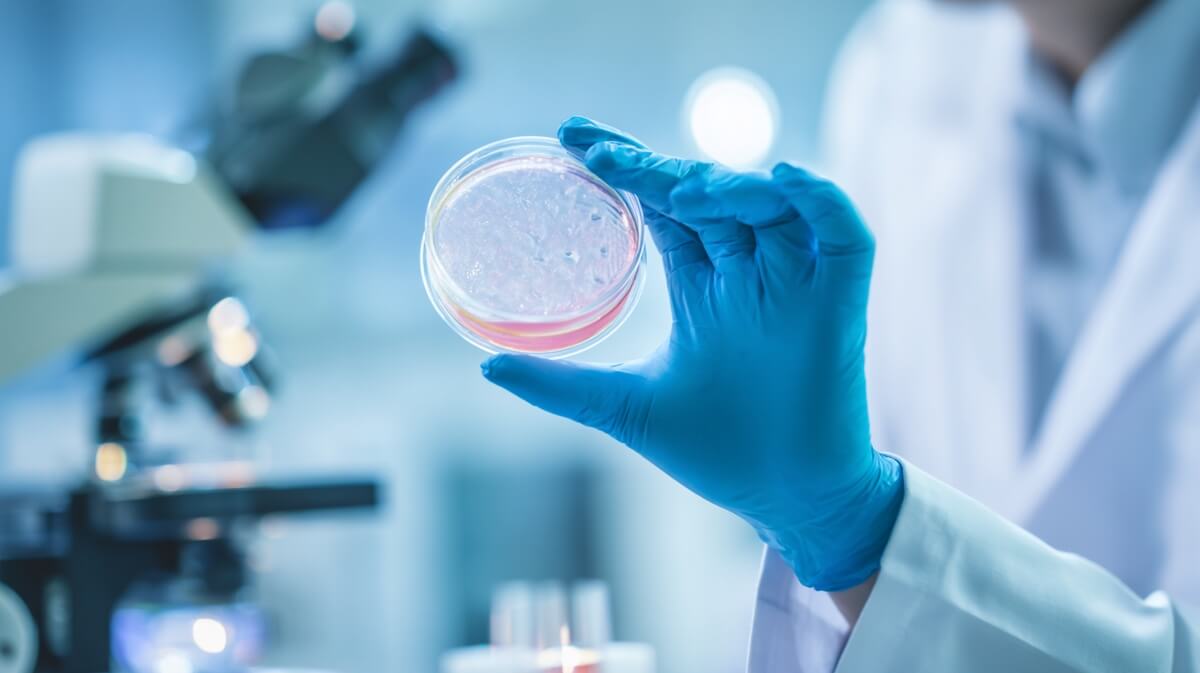
Chercheur examinant des cellules en culture dans un laboratoire de recherche sur le vieillissement © SeniorActu

Ce qu'il faut retenir
- Des chercheurs japonais ont comparé pour la première fois 21 médicaments sénolytiques censés éliminer les cellules sénescentes
- Deux molécules se révèlent nettement supérieures : l'ABT263 (navitoclax) et l'ARV825
- Même avec ces médicaments, 20 à 30% des cellules zombies survivent grâce à leurs mitochondries
- Un régime cétogène ou certains antidiabétiques pourraient renforcer l'efficacité de ces traitements
- Ces médicaments restent au stade de la recherche et ne sont pas disponibles pour le grand public

Chercheur examinant des cellules en culture dans un laboratoire de recherche sur le vieillissement © SeniorActu
Une première mondiale : 21 médicaments passés au crible
Vous avez peut-être entendu parler des « cellules zombies » ? Ce surnom imagé désigne les cellules sénescentes, des cellules qui ont cessé de se diviser mais refusent obstinément de mourir. Le problème ? Elles s'accumulent avec l'âge et sécrètent des substances inflammatoires toxiques pour leurs voisines, un phénomène que les scientifiques appellent le SASP (phénotype sécrétoire associé à la sénescence).
Ces cellules sont aujourd'hui soupçonnées de contribuer à de nombreuses maladies liées à l'âge : athérosclérose, ostéoporose, fibrose pulmonaire, diabète de type 2, et même certaines formes de démence. Des études chez la souris ont montré que leur élimination permettait de retarder l'apparition de ces pathologies et d'augmenter la durée de vie en bonne santé.
Depuis 2015, date à laquelle la Mayo Clinic américaine a identifié les premiers « sénolytiques » (le dasatinib et la quercétine), plus de 20 molécules capables d'éliminer ces cellules indésirables ont été découvertes. Mais jusqu'à présent, personne n'avait réellement comparé leur efficacité respective. C'est chose faite.
L'équipe du professeur Eiji Hara, de l'Institut de recherche sur les maladies microbiennes de l'Université d'Osaka, publie ce jeudi 29 janvier 2026 dans la prestigieuse revue Nature Aging la première comparaison systématique de 21 médicaments sénolytiques. Pour ce faire, les chercheurs ont créé un « indice de spécificité sénolytique » (SSI) permettant de mesurer la capacité de chaque molécule à détruire les cellules sénescentes sans endommager les cellules saines.
Ces cellules sont aujourd'hui soupçonnées de contribuer à de nombreuses maladies liées à l'âge : athérosclérose, ostéoporose, fibrose pulmonaire, diabète de type 2, et même certaines formes de démence. Des études chez la souris ont montré que leur élimination permettait de retarder l'apparition de ces pathologies et d'augmenter la durée de vie en bonne santé.
Depuis 2015, date à laquelle la Mayo Clinic américaine a identifié les premiers « sénolytiques » (le dasatinib et la quercétine), plus de 20 molécules capables d'éliminer ces cellules indésirables ont été découvertes. Mais jusqu'à présent, personne n'avait réellement comparé leur efficacité respective. C'est chose faite.
L'équipe du professeur Eiji Hara, de l'Institut de recherche sur les maladies microbiennes de l'Université d'Osaka, publie ce jeudi 29 janvier 2026 dans la prestigieuse revue Nature Aging la première comparaison systématique de 21 médicaments sénolytiques. Pour ce faire, les chercheurs ont créé un « indice de spécificité sénolytique » (SSI) permettant de mesurer la capacité de chaque molécule à détruire les cellules sénescentes sans endommager les cellules saines.
Deux champions incontestés parmi les 21 candidats
Le verdict est sans appel. Parmi tous les médicaments testés sur des fibroblastes humains et des cellules épithéliales, deux se distinguent nettement par leur efficacité et leur sélectivité :
L'ABT263, aussi connu sous le nom de navitoclax, est un inhibiteur de la famille des protéines Bcl-2. Ces protéines empêchent normalement les cellules de mourir par apoptose (mort cellulaire programmée). En les bloquant, le navitoclax « déverrouille » la capacité des cellules sénescentes à s'autodétruire. Initialement développé comme anticancéreux, il fait déjà l'objet d'essais cliniques de phase 3 pour traiter certaines leucémies et la myélofibrose. Ses propriétés sénolytiques avaient été identifiées dès 2016.
L'ARV825 est un inhibiteur BET (bromodomain and extraterminal domain) qui agit différemment. Il cible la réparation de l'ADN et l'autophagie des cellules sénescentes. Cette molécule, développée par l'équipe du professeur Hara elle-même, reste pour l'instant au stade préclinique, c'est-à-dire qu'elle n'a pas encore été testée chez l'humain.
Ces deux composés ont démontré la meilleure capacité à éliminer les cellules sénescentes tout en préservant les cellules normales. Une performance que les autres sénolytiques, y compris le fameux duo dasatinib-quercétine découvert en 2015, n'ont pas égalée dans ces conditions expérimentales.
L'ABT263, aussi connu sous le nom de navitoclax, est un inhibiteur de la famille des protéines Bcl-2. Ces protéines empêchent normalement les cellules de mourir par apoptose (mort cellulaire programmée). En les bloquant, le navitoclax « déverrouille » la capacité des cellules sénescentes à s'autodétruire. Initialement développé comme anticancéreux, il fait déjà l'objet d'essais cliniques de phase 3 pour traiter certaines leucémies et la myélofibrose. Ses propriétés sénolytiques avaient été identifiées dès 2016.
L'ARV825 est un inhibiteur BET (bromodomain and extraterminal domain) qui agit différemment. Il cible la réparation de l'ADN et l'autophagie des cellules sénescentes. Cette molécule, développée par l'équipe du professeur Hara elle-même, reste pour l'instant au stade préclinique, c'est-à-dire qu'elle n'a pas encore été testée chez l'humain.
Ces deux composés ont démontré la meilleure capacité à éliminer les cellules sénescentes tout en préservant les cellules normales. Une performance que les autres sénolytiques, y compris le fameux duo dasatinib-quercétine découvert en 2015, n'ont pas égalée dans ces conditions expérimentales.
Le mystère des cellules zombies qui résistent aux traitements
Mais la découverte ne s'arrête pas là. Les chercheurs ont fait une observation cruciale : même avec les meilleurs sénolytiques, et même après un traitement prolongé de 7 jours, 20 à 30% des cellules sénescentes survivent. Pourquoi certaines résistent-elles alors que d'autres succombent ?
La réponse se trouve dans leurs mitochondries, ces petites « centrales énergétiques » présentes dans chaque cellule. Grâce à des analyses de séquençage ARN sur cellule unique, l'équipe japonaise a découvert que les cellules zombies survivantes possèdent des mitochondries en meilleur état que les autres. Elles parviennent à éliminer leurs mitochondries endommagées grâce à une enzyme appelée V-ATPase, ce qui les protège de l'accumulation de radicaux libres et donc de la mort cellulaire.
En d'autres termes, les cellules sénescentes ne sont pas toutes identiques. Certaines, mieux équipées sur le plan mitochondrial, échappent au traitement. Cette hétérogénéité était jusqu'ici méconnue et explique en partie les résultats variables des sénolytiques observés dans les études précédentes.
Cette découverte ouvre une piste thérapeutique inattendue. En imposant un « stress » supplémentaire aux mitochondries, les chercheurs ont réussi à augmenter l'efficacité des sénolytiques. Chez la souris, deux approches ont fonctionné : le régime cétogène (très pauvre en glucides, forçant les cellules à utiliser leurs mitochondries) et les inhibiteurs SGLT2, des médicaments antidiabétiques déjà commercialisés comme la dapagliflozine.
La réponse se trouve dans leurs mitochondries, ces petites « centrales énergétiques » présentes dans chaque cellule. Grâce à des analyses de séquençage ARN sur cellule unique, l'équipe japonaise a découvert que les cellules zombies survivantes possèdent des mitochondries en meilleur état que les autres. Elles parviennent à éliminer leurs mitochondries endommagées grâce à une enzyme appelée V-ATPase, ce qui les protège de l'accumulation de radicaux libres et donc de la mort cellulaire.
En d'autres termes, les cellules sénescentes ne sont pas toutes identiques. Certaines, mieux équipées sur le plan mitochondrial, échappent au traitement. Cette hétérogénéité était jusqu'ici méconnue et explique en partie les résultats variables des sénolytiques observés dans les études précédentes.
Cette découverte ouvre une piste thérapeutique inattendue. En imposant un « stress » supplémentaire aux mitochondries, les chercheurs ont réussi à augmenter l'efficacité des sénolytiques. Chez la souris, deux approches ont fonctionné : le régime cétogène (très pauvre en glucides, forçant les cellules à utiliser leurs mitochondries) et les inhibiteurs SGLT2, des médicaments antidiabétiques déjà commercialisés comme la dapagliflozine.
Des résultats prometteurs mais encore loin de votre pharmacie
Les résultats obtenus chez la souris sont encourageants. La combinaison d'un régime cétogène avec l'ABT263 ou l'ARV825 a permis de réduire significativement les métastases de mélanome dans les poumons de souris âgées. Les chercheurs ont également observé une diminution de certaines molécules inflammatoires (CXCL2 et CXCL12) connues pour favoriser la migration des cellules cancéreuses. De même, associés à un inhibiteur SGLT2, ces sénolytiques ont mieux freiné la croissance de tumeurs colorectales.
Faut-il pour autant commander du navitoclax sur Internet ou se lancer dans un régime cétogène strict ? Absolument pas. Ces médicaments ne sont pas approuvés pour un usage anti-âge et présentent des effets secondaires potentiellement graves. Le navitoclax provoque notamment une thrombocytopénie (baisse des plaquettes sanguines) qui limite son utilisation. Le régime cétogène prolongé comporte également des risques, particulièrement pour les personnes âgées ou diabétiques, pouvant aller jusqu'à l'acidocétose.
Cette étude constitue néanmoins une avancée majeure dans la compréhension des mécanismes du vieillissement cellulaire. Elle ouvre la voie à des « thérapies sénolytiques combinées » plus efficaces, adaptant le traitement à la résistance des cellules ciblées. Mais le professeur Hara et son équipe le rappellent : plusieurs années de recherche et d'essais cliniques seront encore nécessaires avant qu'un traitement anti-cellules zombies n'arrive en pharmacie. En attendant, les meilleurs conseils restent les plus classiques : activité physique régulière, alimentation équilibrée et suivi médical.
Faut-il pour autant commander du navitoclax sur Internet ou se lancer dans un régime cétogène strict ? Absolument pas. Ces médicaments ne sont pas approuvés pour un usage anti-âge et présentent des effets secondaires potentiellement graves. Le navitoclax provoque notamment une thrombocytopénie (baisse des plaquettes sanguines) qui limite son utilisation. Le régime cétogène prolongé comporte également des risques, particulièrement pour les personnes âgées ou diabétiques, pouvant aller jusqu'à l'acidocétose.
Cette étude constitue néanmoins une avancée majeure dans la compréhension des mécanismes du vieillissement cellulaire. Elle ouvre la voie à des « thérapies sénolytiques combinées » plus efficaces, adaptant le traitement à la résistance des cellules ciblées. Mais le professeur Hara et son équipe le rappellent : plusieurs années de recherche et d'essais cliniques seront encore nécessaires avant qu'un traitement anti-cellules zombies n'arrive en pharmacie. En attendant, les meilleurs conseils restent les plus classiques : activité physique régulière, alimentation équilibrée et suivi médical.
Sources :
- Nature Aging, « Comparative analysis of senolytic drugs reveals mitochondrial determinants of efficacy and resistance », Wakita et al., 29 janvier 2026
- Research Institute for Microbial Diseases, Osaka University, Hara Lab
- Nature Aging, « Comparative analysis of senolytic drugs reveals mitochondrial determinants of efficacy and resistance », Wakita et al., 29 janvier 2026
- Research Institute for Microbial Diseases, Osaka University, Hara Lab